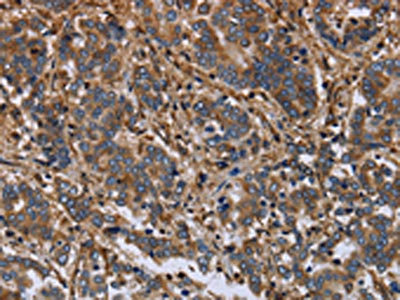

FLNA Antibody
-
中文名稱:FLNA兔多克隆抗體
-
貨號:CSB-PA985162
-
規格:¥1100
-
圖片:
-
The image on the left is immunohistochemistry of paraffin-embedded Human liver cancer tissue using CSB-PA985162(FLNA Antibody) at dilution 1/40, on the right is treated with fusion protein. (Original magnification: ×200)
-
The image on the left is immunohistochemistry of paraffin-embedded Human brain tissue using CSB-PA985162(FLNA Antibody) at dilution 1/40, on the right is treated with fusion protein. (Original magnification: ×200)
-
Gel: 6%SDS-PAGE, Lysate: 40 μg, Lane 1-4: PC3 cells, Hela cells, NIH/3T3 cells, HUVEC cells, Primary antibody: CSB-PA985162(FLNA Antibody) at dilution 1/800, Secondary antibody: Goat anti rabbit IgG at 1/8000 dilution, Exposure time: 1 minute
-
-
其他:
產品詳情
-
Uniprot No.:
-
基因名:
-
別名:ABP 280 antibody; ABP-280 antibody; Actin-binding protein 280 antibody; Alpha filamin antibody; Alpha-filamin antibody; APBX antibody; CSBS antibody; CVD1 antibody; Endothelial actin binding protein antibody; Endothelial actin-binding protein antibody; Filamin 1 antibody; Filamin A alpha antibody; Filamin A antibody; Filamin-1 antibody; Filamin-A antibody; FLN antibody; FLN-A antibody; FLN1 antibody; FLNA antibody; FLNA_HUMAN antibody; FMD antibody; MNS antibody; NHBP antibody; Non muscle filamin antibody; Non-muscle filamin antibody; OPD antibody; OPD1 antibody; OPD2 antibody; XLVD antibody; XMVD antibody
-
宿主:Rabbit
-
反應種屬:Human,Mouse
-
免疫原:Fusion protein of Human FLNA
-
免疫原種屬:Homo sapiens (Human)
-
標記方式:Non-conjugated
-
抗體亞型:IgG
-
純化方式:Antigen affinity purification
-
濃度:It differs from different batches. Please contact us to confirm it.
-
保存緩沖液:-20°C, pH7.4 PBS, 0.05% NaN3, 40% Glycerol
-
產品提供形式:Liquid
-
應用范圍:ELISA,WB,IHC
-
推薦稀釋比:
Application Recommended Dilution ELISA 1:2000-1:5000 WB 1:500-1:2000 IHC 1:50-1:200 -
Protocols:
-
儲存條件:Upon receipt, store at -20°C or -80°C. Avoid repeated freeze.
-
貨期:Basically, we can dispatch the products out in 1-3 working days after receiving your orders. Delivery time maybe differs from different purchasing way or location, please kindly consult your local distributors for specific delivery time.
-
用途:For Research Use Only. Not for use in diagnostic or therapeutic procedures.
相關產品
靶點詳情
-
功能:Promotes orthogonal branching of actin filaments and links actin filaments to membrane glycoproteins. Anchors various transmembrane proteins to the actin cytoskeleton and serves as a scaffold for a wide range of cytoplasmic signaling proteins. Interaction with FLNB may allow neuroblast migration from the ventricular zone into the cortical plate. Tethers cell surface-localized furin, modulates its rate of internalization and directs its intracellular trafficking. Involved in ciliogenesis. Plays a role in cell-cell contacts and adherens junctions during the development of blood vessels, heart and brain organs. Plays a role in platelets morphology through interaction with SYK that regulates ITAM- and ITAM-like-containing receptor signaling, resulting in by platelet cytoskeleton organization maintenance. During the axon guidance process, required for growth cone collapse induced by SEMA3A-mediated stimulation of neurons.
-
基因功能參考文獻:
- The authors describe a family with a novel FLNA mutation with a male-expressed, apparently isolated, cardiac phenotype with no skewed X-inactivation pattern in female carriers. PMID: 29146485
- silencing filamin A may inhibit the invasion and migration of breast cancer cells by upregulating 14-3-3sigma. PMID: 30074213
- FLNA overexpression suppressed the proliferation of Bladder Carcinoma cells, blocked cell cycle and promoted apoptosis of Bladder Carcinoma cell. PMID: 29288417
- Silencing filamin A (FLNa) expression in lung cancer cell line A549 cells promoted proliferation, migration, and invasiveness of A549 cells by enhancing the activation of epidermal growth factor receptor and ERK signaling pathway. PMID: 29272322
- Reduced RNA editing of FLNA gene is associated with psoriasis. PMID: 29592874
- Data indicate mutations in FLNA (Filamin A) associated with Ebstein anomaly. PMID: 29237676
- these observations describe a new mechanism of tissue-specific regulation of FLNA that could reflect the differing mechanical requirements of these cell types during development. PMID: 29024177
- This study also indicates that FLNA may affect white matter integrity in patients with periventricular nodular heterotopia related epilepsy. PMID: 29062687
- The mutations of the FLNA gene were observed in 7 (30.4%) of the 23 patients who with Sporadic periventricular nodular heterotopia. PMID: 28411558
- Data show that AR-deficient and highly metastatic prostate cancer cell lines express higher levels of filamin A compared to normal prostate epithelial cells and AR-positive and less metastatic prostate cancer. Also, the results identified that Cao2+ via CaR-mediated signaling induces filamin A cleavage and promotes the migration in AR-deficient and highly metastatic prostate cancer cells. PMID: 27206800
- FLNA is downregulated in parathyroid tumors and parallels the CASR expression levels. Loss of FLNA reduces CASR mRNA and protein expression levels and the CASR-induced ERK phosphorylation. FLNA is involved in receptor expression, membrane localization and ERK signaling activation of both 990R and 990G CASR variants. PMID: 27872158
- We report two brothers carrying a loss-of-function mutation of FNLA with gonadal differentiation disorder and hypospadias. Specific staining for AR shows almost an absolute absence of these receptors in the testicular tissue. PMID: 28432720
- Lowering the FLNA level elevated RalA activity and resulted in selective interference with the normal intracellular trafficking and signaling of the D2R and D3R, through GRK2 and beta-arrestins, respectively. FLNA is a multi-functional protein that acts as a platform on which D2R and D3R can interact with various proteins causing selective regulation of these receptors occurs in combination with GRK2 and beta-arrestins. PMID: 27188791
- FLNA upregulation correlates with Snail-induced epithelial to mesenchymal transition in colorectal carcinoma. PMID: 28778796
- Our findings expand the male-specific phenotype of FLNA mutations that now includes classical-like EDS with lethal cardiac valvular dystrophy, and offer further insights for the genotype-phenotype correlations within this spectrum. PMID: 27739212
- Study identifies ANXA4 and FLNA as up-regulated in buccal squamous cell carcinoma arising from oral submucous fibrosis. PMID: 27485544
- These results provide new insights into the regulation of SK2 channel trafficking by the cytoskeletal proteins FLNA and alpha-actinin2, involving distinct recycling pathways PMID: 27779751
- Respiratory failure secondary to progressive obstructive lung disease during infancy may be the presenting phenotype of FLNA-associated periventricular nodular heterotopia. PMID: 28457522
- The actin regulator FLNA interacts with the endoplasmic reticulum stress kinase PERK and this interaction is required for the efficient formation of ER-plasma membrane contact sites. PMID: 28238652
- CCR2B and beta2AR signals to FLNa to stimulate its endocytosis and recycling to the plasma membrane. PMID: 27909248
- In humans, mutations in the actin-binding protein Filamin-C result in myopathies, but the underlying molecular function is not well understood. Here we show using Drosophila indirect flight muscle that the filamin ortholog Cheerio in conjunction with the giant elastic protein titin plays a crucial role in keeping thin filaments stably anchored at the Z-disc PMID: 28732005
- Case Report: Reduced binding of mutant FLNa to beta3 and the facilitated recruitment of talin by beta3 on platelet stimulation, explaining the increased alphaIIbbeta3 activation and the ensuing gain-of-platelet functions. PMID: 28428218
- results reveal an unusual structural and thermodynamic basis for the P2204L-induced dysfunction of filamin and frontometaphyseal dysplasia disease. PMID: 28348077
- Mechanistic analysis revealed that FLNA suppresses pol III gene transcription by confining the recruitment of the RNA pol III transcription machinery at the promoters of the genes that are sensitive to the alteration of FLNA expression. PMID: 27738102
- FlnA more strongly binds RhoA, although both filamins overlap with RhoA expression in the cell cytoplasm. FlnA promotes RhoA activation whereas FlnB indirectly inhibits this pathway. Moreover, FlnA loss leads to diminished expression of b1-integrin, whereas FlnB loss promotes integrin expression PMID: 28175289
- FLNA can function as a modulator of chemosensitivity to docetaxel in triple-negative breast cancer (TNBC) cells through regulation of the MAPK/ERK pathway both in vitro and in vivo. FLNA may serve as a novel therapeutic target for improvement of chemotherapy efficacy in TNBC. PMID: 26546439
- Results indicate that mTORC2 regulates filamin A-dependent focal adhesions and cell migration. PMID: 27059097
- The syndrome affecting the family shares phenotypic overlap with other syndromes caused by FLNA mutations, but appears to be a distinct phenotype, likely representing a unique genetic syndrome. PMID: 26804200
- The findings in these cases are distinct from previously described FLNA related disorders by virtue of decreased joint mobility and spontaneous keloid scarring. They occur in association with a novel mutation and represent a novel genetic syndrome. PMID: 26686323
- FLNA gene mutation analysis was performed in a series of 10 fetuses and a neonatally deceased newborn displaying a multiple congenital anomalies syndrome suggestive of otopalatodigital spectrum disorders. PMID: 26404489
- This study expands the diversity of the phenotypes associated with loss-of-function mutations in FLNA. PMID: 26059841
- Filamin-A is required to mediate SSTR2 effects in pancreatic neuroendocrine tumours PMID: 26733502
- The function of different integrins is subjected to differential regulation by FLNa. PMID: 26572583
- FLNA functions as a positive cellular transducer linking actin polymerization to MKL1-SRF activity, counteracting the known repressive complex of MKL1 and monomeric G-actin. PMID: 26554816
- Missense substitutions in FLNA were identified in four unrelated craniosynostosis patients. PMID: 25873011
- studies suggest that Vpu hijacks the FLNa function in the modulation of tetherin to neutralize the antiviral factor tetherin. PMID: 26742839
- Our interpretation of these contradictions is that truncation and/or mutation of RhoGDI2 perturbs its conformation to expose a site that adventitiously binds FLNA and is not a bona-fide interaction. PMID: 26707877
- Extracellular sphingosine-1-phosphate activates NF-kappaB only in melanoma cells that lack FLNA. PMID: 26552704
- FLNA anchors PC2 to the actin cytoskeleton through complex PC2-FLNA-actin to reduce degradation and increase stability, and possibly regulate PC2 function in a Ca-dependent manner. PMID: 25861040
- These observations imply that other interactions apart from those mediated by the canonical repeat 24 dimerisation interface contribute to FLNA homodimerization and that mutations affecting this region of the protein can have broad phenotypic effects. PMID: 25686753
- Our results support FLNA as a new downstream effector of mTORC2 controlling GBM cell motility. PMID: 26134617
- Familial periventricular nodular heterotopia, epilepsy and Melnick-Needles Syndrome caused by a single FLNA mutation with combined gain-of-function and loss-of-function effects PMID: 25755106
- The data suggest a molecular mechanism for direct G protein-coupled receptors -cytoskeleton coupling via filamin A. PMID: 26460884
- Frontometaphyseal dysplasia and keloid formation without normally present in this condition FLNA mutations have been described in six unrelated children patients. PMID: 25899317
- FLNA analysis was performed by DHPLC followed by Sanger sequencing [Robertson et al., 2006]. Both sisters were heterozygous for a novel mutation, c.6611C>T in exon 41, that predicts the substitution p.Pro2204Leu within filamin repeat 20 PMID: 25820619
- FLNa showed low expression in colorectal adenocarcinoma, high correlation with the incidence and development of colorectal cancer, and was considered an indicator of prognosis. PMID: 25717257
- The androgen-triggered AR/filamin A complex controls, through Rac 1, the decision of cells to halt cell cycle and migration. PMID: 25476896
- Virus infection and RNase L activation disrupt its association with Filamin A and release RNase L to mediate its canonical nuclease-dependent antiviral activities. PMID: 25352621
- Autoinhibited filamin is refractory to phosphorylation by PKA on a known Ser(2152) site despite its consensus motif being exposed and the corresponding isolated peptide being readily phosphorylated. PMID: 25666618
- this study proposes that FLNA interaction with ICL3(intracellular loop) is central for endocytosis and signaling of WT and WHIM-like CXCR4 receptors. PMID: 25355818
顯示更多
收起更多
-
相關疾病:Periventricular nodular heterotopia 1 (PVNH1); Otopalatodigital syndrome 1 (OPD1); Otopalatodigital syndrome 2 (OPD2); Frontometaphyseal dysplasia 1 (FMD1); Melnick-Needles syndrome (MNS); Intestinal pseudoobstruction, neuronal, chronic idiopathic, X-linked (IPOX); FG syndrome 2 (FGS2); Terminal osseous dysplasia (TOD); Cardiac valvular dysplasia X-linked (CVDX); Congenital short bowel syndrome, X-linked (CSBSX)
-
亞細胞定位:Cytoplasm, cell cortex. Cytoplasm, cytoskeleton. Perikaryon. Cell projection, growth cone.
-
蛋白家族:Filamin family
-
組織特異性:Ubiquitous.
-
數據庫鏈接:
Most popular with customers
-
YWHAB Recombinant Monoclonal Antibody
Applications: ELISA, WB, IHC, IF, FC
Species Reactivity: Human, Mouse, Rat
-
Phospho-YAP1 (S127) Recombinant Monoclonal Antibody
Applications: ELISA, WB, IHC
Species Reactivity: Human
-
-
-
-
-
-